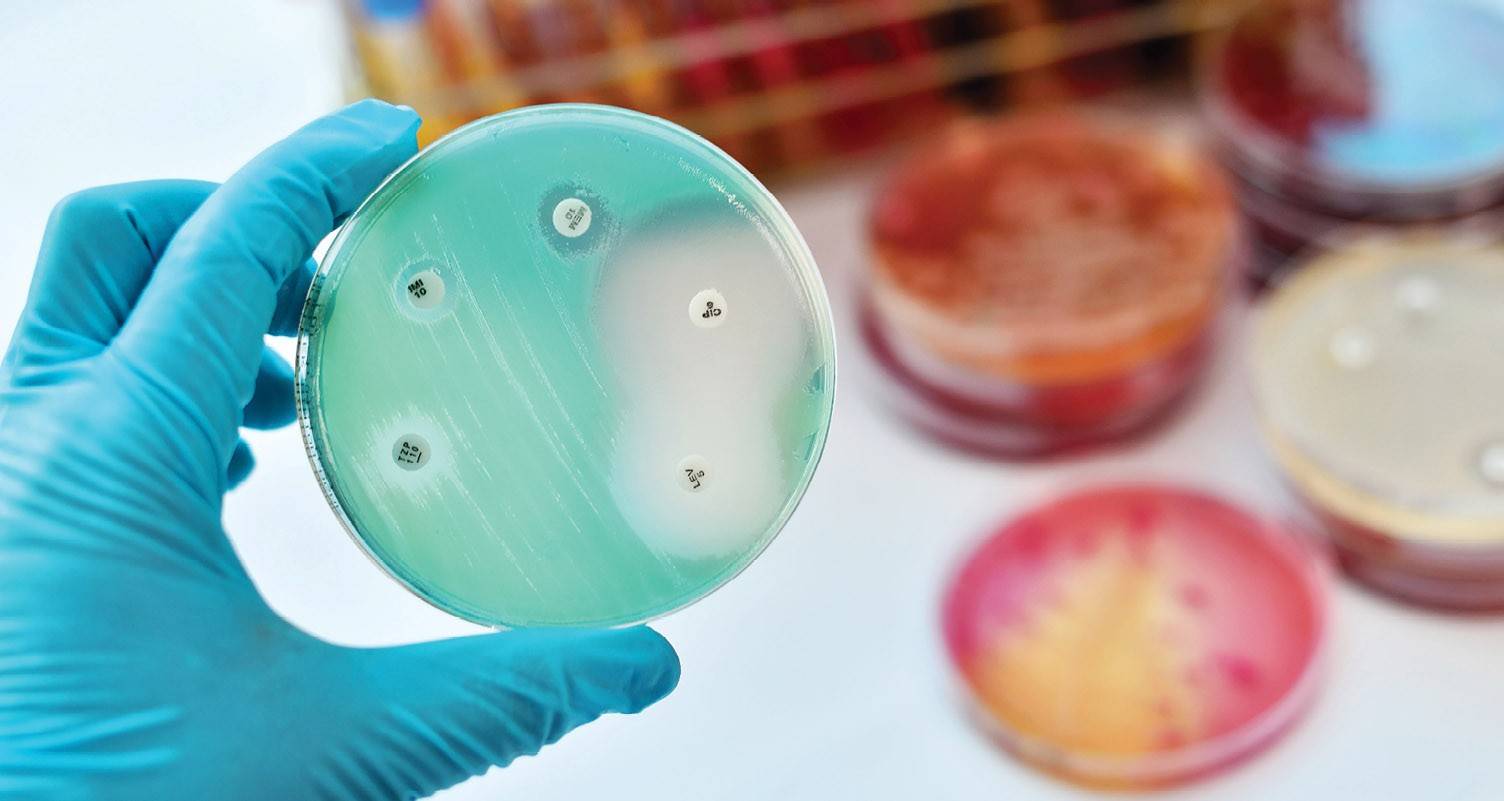

Основа препарата
2 штамма спорообразующих бактерий Bacillus amyloliquefaciens, штамм бактерийPseudomonas brassicacearum, штамм азотфиксирующих бактерий Brevibacillus sp., штамм фосфатмобилизующих бактерий Bacillus megaterium; титр – не менее 1,0×109КОЕ/мл
Эффективность, принцип действия
- подавляет развитие патогенной микрофлоры и обеспечивает восстановление агробиоценозов, стимулирует жизнедеятельность микроорганизмов основных эколого-трофических групп почвы;
- ускоряет разложение растительных остатков в почве: коэффициент минерализации пожнивно-корневых остатков зерновых культур в 3,7 разапревышает контрольные показатели;
- обогащает почву усвояемым фосфором и азотом;
- повышает плодородие почвы и урожайность сельскохозяйственных культур на10-27%;
- применение микробного препарата Полибакт позволяет снизить количество вносимых химических пестицидов и минеральных удобрений, обеспечивает получение экологически чистой продукции с наименьшими затратами.
Рекомендации по применению
Норма расхода | Особенности обработки | Кратность | |
Обработка стерни | 3 л препарата | Почву и равномерно распределенные по полю растительные остатки обрабатывают водной суспензией препарата аэрозольным способом. Обработку проводят вечером или в пасмурную погоду. Влажность почвы в момент обработки должна быть не менее 60% на глубине до 10-12 см. После обработки почву задисковывают на глубину 5-15 см. Период времени между внесением препарата и его заделкой в почву должен быть минимальным (не более 3-5 ч) |
Действие Байкала ЭМ1 на урожай и качество корнеплодов сахарной свеклы
Варианты | Урожай-ность, т/га | Сахарис-тость, % | α-N, ммоль/кг свеклы | Расчетный выход сахара, т/га | Прибыль тыс. руб/га | Рентабельность, % |
1. Контроль | 56,7 | 17,31 | 8,0 | 8,6 | ||
2. Байкал (после уборки предшественника осенью) | 55,8 | 17,40 | 9,5 | 8,5 | ||
3. Байкал (после уборки предшественника осенью) + Байкал (под п/пос. культивацию) | 64,3 | 17,46 | 7,4 | 9,9 | 160 | 38 |
4. Байкал (после уборки предшественника осенью) + Байкал (под п/пос. культивацию) + Байкал (в некорневую подкормку) | 65,0 | 17,17 | 8,6 | 9,8 | 109 | 21 |
5. Байкал (под п/пос. культивацию) | 64,3 | 17,36 | 7,9 | 9,9 | 241 | 70 |
6. Байкал (под п/пос. культивацию) + Байкал (в некорневую подкормку) | 64,6 | 17,41 | 8,9 | 9,9 | 173 | 40 |
7. Байкал (в некорневую подкормку) | 55,0 | 17,47 | 8,5 | 8,5 | ||
8. КАС 100 л/га (после уборки предшественника осенью) | 63,6 | 17,18 | 8,3 | 9,6 | 247 | 87 |
НСР05 | 6,9 | 0,35 | 1,6 | 1,0 |
Весеннее внесение Байкала ЭМ1 под предпосевную культивацию достоверно повышало урожай корнеплодов.
Осенью для минерализации растительных остатков предпочтительно применять КАС.